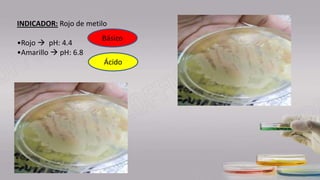
Ácido
Básico
INDICADOR: Rojo de metilo
•Rojo  pH: 4.4
•Amarillo  pH: 6.8

El documento describe un estudio sobre el metabolismo de lípidos por bacterias. Se explican las rutas de degradación de diferentes tipos de lípidos como triglicéridos y fosfolípidos a través de enzimas como lipasas y fosfolipasas. La β-oxidación convierte los ácidos grasos en acetil-CoA, generando energía en forma de ATP. Los productos pueden ingresar a la glucólisis o al ciclo de Krebs. Se mencionan las condiciones óptimas para estas rutas metabólicas.